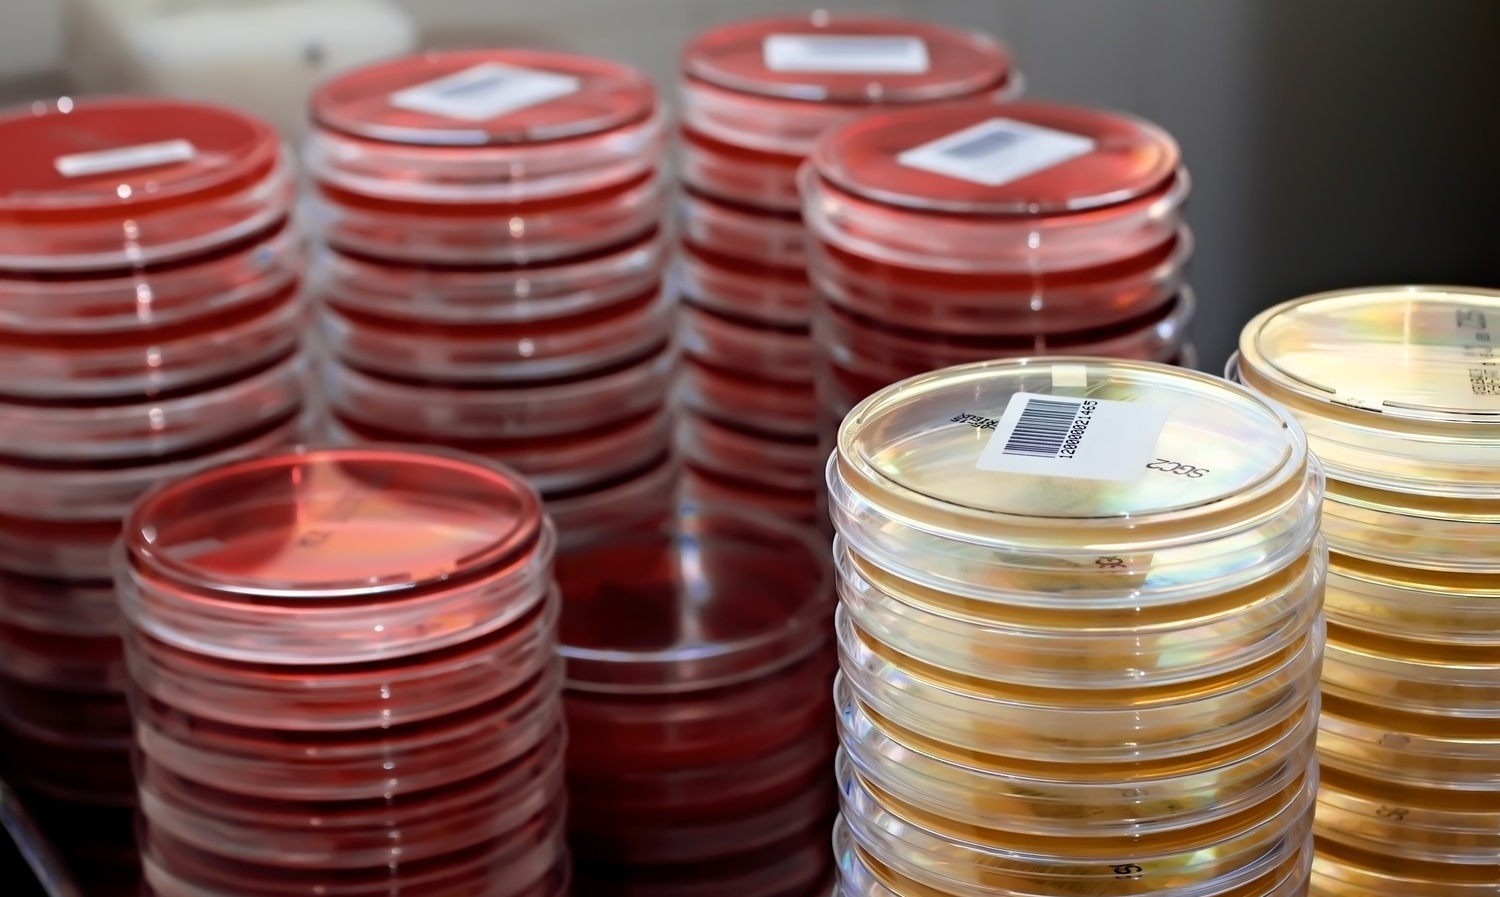
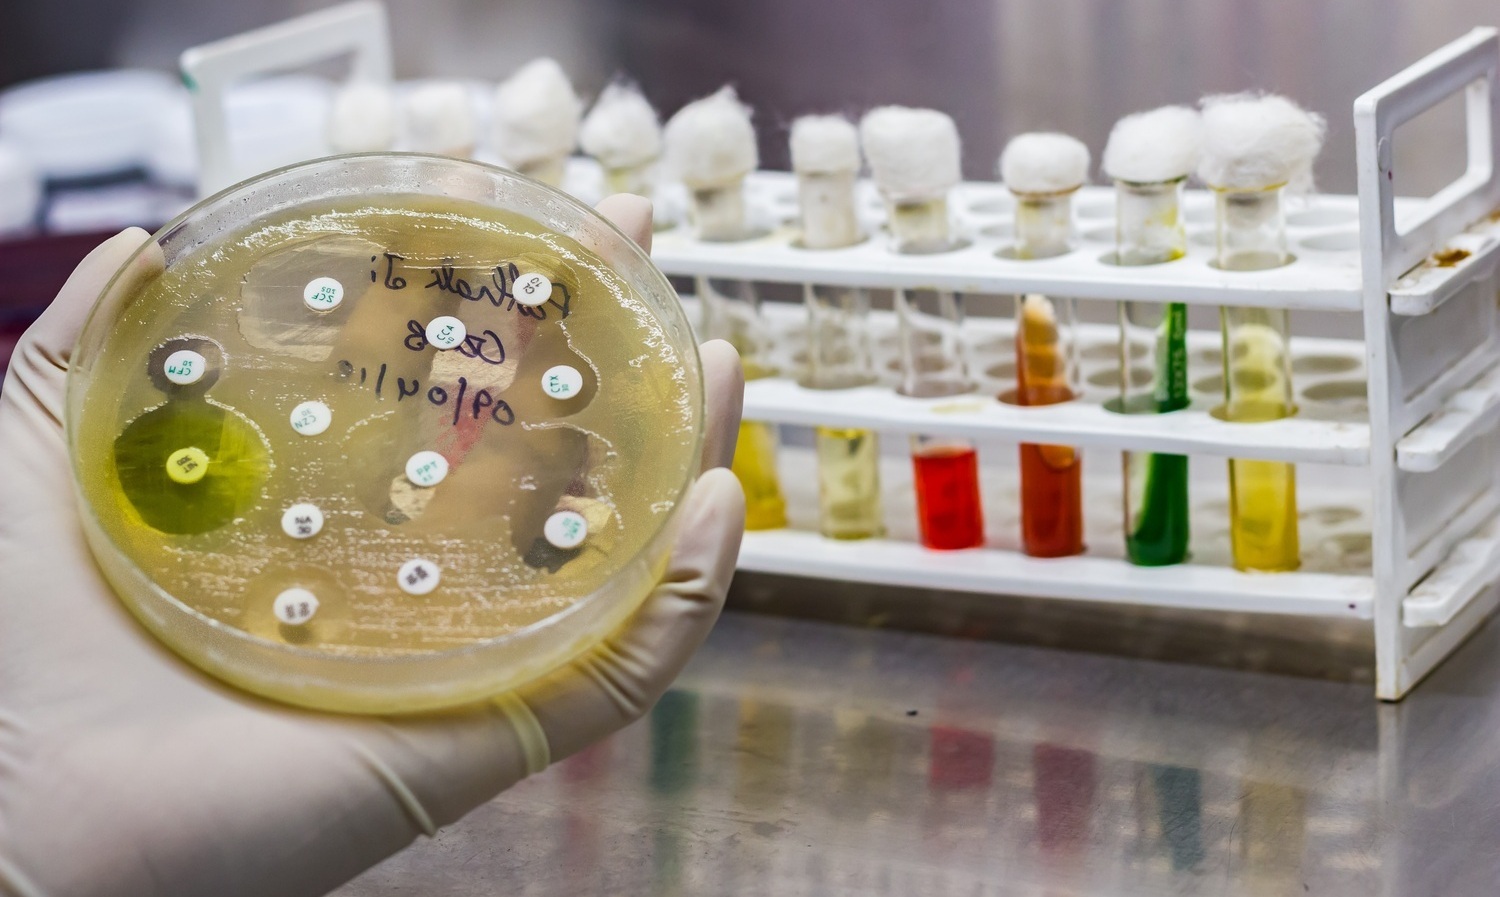

Основные направления деятельности Обл-Био
Услуги компании
Обл-Био
Компания осуществляет выпуск:
• в капсюльной форме (упаковка баночка пластиковая, блистер)
• в таблет форме (упаковка баночка пластиковая, блистер)
•форма выпуска медицинский флакон лиофилизат/жидкая форма/сухая рассыпка (картонная коробка, укладка флакона в запаянный фольгой пластиковый ложемент)
•сухой порошок (вакуумный пакет из плёнок либо фольгированных плёнок)
• саше форма сухой порошок (до 30 гр.)
А так же все сопутствующее оборудование для производства ЛЮБЫХ форм выпуска: лакто, бифидо бактерий, заквасок и прочей микробиологической продукции.
Вы выбрали услугу или не можете определится с выбором? Напишите нам!
Обратная связь

ООО "Обл-Био"
ООО "Обл-Био" основано в 2003 г. на базе Научно-производственного комплекса ВНИИ ПМ, расположенного в рп. Оболенск, го. Серпухов, Московской области.
ООО "Обл-Био" биотехнологическая динамически развивающаяся компания, сотрудничает с микробиологическими заводами России. Располагает всей необходимой инфраструктурой и квалифицированным персоналом в области микробиологии и биотехнологии для проведения биотехнологических и исследовательских работ любой сложности. Работает по стандартам ISO 9001.
Компания занимается производством биосубстанций. Производит препараты ветеринарного применения. У компании имеются разработки в сфере экологии, а так же оптимизации промышленной микробиологии. Осуществляет изготовление сложнейшего оборудования для обеспечения собственных нужд. Оказывает услуги по культивированию промышленных микроорганизмов лиофильно высушенных.
На базе Обл-Био, разработаны и внедрены в производство биопрепараты:
- Лекарственного направления (антибиотики, гастроэнтологические);
- Ферментативные препараты;
- Биоактивные добавки для пищевой промышленности;
- Биодеструкторы;
- Компоненты для буровых растворов полученные биотехнологическим методом;
- Средства защиты растений;
- Разработана и внедрена технология производства молочных заквасок для жидких и твердых товарных форм.
Контакты компании — ОбиоЛаб
Контактная информация компании — Обл-Био
Фактический адрес
- ООО « ОбиоЛаб », 142279 МО, г.о. Серпухов, гп. Оболенск, Корпус 7 "А", Московская обл, г Серпухов, поселок Оболенск, тер Квартал Б, д 13а, 142279
- +7 (495) 847-07-99
- obiolab@yandex.ru, info@obl-bio.com
Почтовый адрес
- ООО « ОбиоЛаб », 142281, МО, г. Протвино, а/я 1528
Социальные сети и мессенджеры
Друзья, на наших страничках в социальных сетях вы сможете ознакомиться со всеми новостями и самыми свежими фотографиями а также пишите нам в удобный для Вас мессенджер.
Информация о компании — Обл-Био
Не находите нужной информации? Напишите нам!
Консультация
© Company — ООО "Обл-Био"